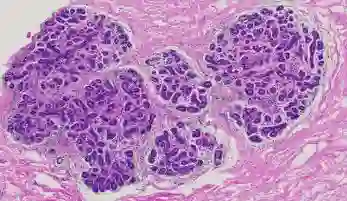

Objective: We develop a computer-aided diagnosis (CAD) system using deep learning approaches for lesion detection and classification on whole-slide images (WSIs) with breast cancer. The deep features being distinguishing in classification from the convolutional neural networks (CNN) are demonstrated in this study to provide comprehensive interpretability for the proposed CAD system using pathological knowledge. Methods: In the experiment, a total of 186 slides of WSIs were collected and classified into three categories: Non-Carcinoma, Ductal Carcinoma in Situ (DCIS), and Invasive Ductal Carcinoma (IDC). Instead of conducting pixel-wise classification into three classes directly, we designed a hierarchical framework with the multi-view scheme that performs lesion detection for region proposal at higher magnification first and then conducts lesion classification at lower magnification for each detected lesion. Results: The slide-level accuracy rate for three-category classification reaches 90.8% (99/109) through 5-fold cross-validation and achieves 94.8% (73/77) on the testing set. The experimental results show that the morphological characteristics and co-occurrence properties learned by the deep learning models for lesion classification are accordant with the clinical rules in diagnosis. Conclusion: The pathological interpretability of the deep features not only enhances the reliability of the proposed CAD system to gain acceptance from medical specialists, but also facilitates the development of deep learning frameworks for various tasks in pathology. Significance: This paper presents a CAD system for pathological image analysis, which fills the clinical requirements and can be accepted by medical specialists with providing its interpretability from the pathological perspective.
翻译:目标:我们开发了一个计算机辅助诊断系统(CAD),使用深层学习方法对乳癌的全滑动图像进行病理检测和分类。本研究展示了在分类中与卷状神经网络(CNN)有区别的深层特征,以便利用病理学知识为拟议的CAD系统提供全面解释。方法:在实验中,共收集了186张WSI幻灯片,并分为三类:非癌症、西图(DCIS)的Ductaal深层肿瘤检测和分类;以及入侵杜氏癌肿瘤(IDC)。我们设计了一个等级框架,在分类中直接将病理学分类分为三类。我们设计了一个等级框架,在分类中,对高放大度区域建议进行腐蚀性检测,然后对每检测的腐蚀性进行腐蚀性分类。结果:三类分类的幻灯片准确率仅达90.8%(99/109至5倍跨度鉴定,对于精度框架则达到94.8%(73/77),而不是在测试中直接进行。实验性分类分析,这一结果结果显示:通过CADreal dealalal deal deal dealalalation 解释系统可以理解性分析。通过Cdeal deal deal deal deal deal deal deal deal deal deal deal deal deal deal deal deal deal deal deal deal deal deal deal deal deal deal deal deal deal deal deal deal deal deal deal dal dal deal deal disal deal deal deal deal deal deal deal deal deal decument sm sal sal sal ex sal ex sal ex sal sal sal sal sal sal sal sal sal sal ex sal sal ex sal sal sm sal sal sal sal sal sal ex sal sal sal sal sal sal sal sal sal sal sal sal sal sal sal sal ex sal sal ex sal sal sal sal sal sal sal sal sal sal sal sal sal sal sal sal